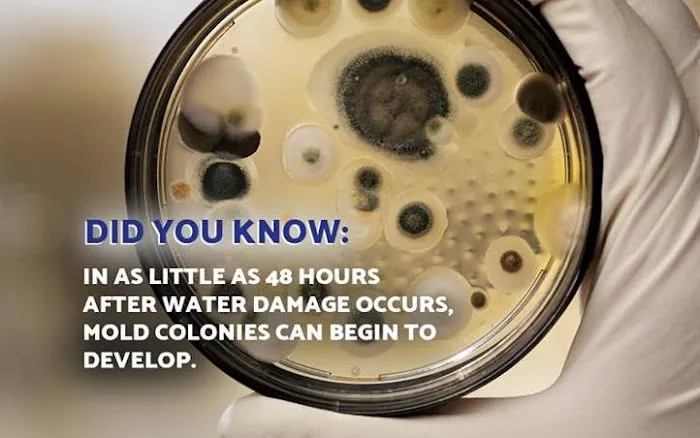
DISS Picture 2

DISS Photos

DISS Introduce
When disaster strikes your property in Western Pennsylvania, finding a trustworthy and comprehensive general contractor is your number one priority. For homeowners and business owners across the region, DISS stands out as a full-service emergency restoration and contracting company, ready to handle the full scope of recovery from initial cleanup to final reconstruction. Operating with decades of experience and a strong commitment to the local communities, DISS offers a wide array of services designed to restore your property—and your peace of mind—after unexpected damage. They are not just focused on cleanup; as a full-service general contractor, they manage all necessary repairs and reconstruction, ensuring a seamless and complete return to pre-loss condition for both residential and commercial structures.
The scope of a true general contractor goes far beyond simple repairs. It means having the expertise to manage a complex project from start to finish, coordinating every trade and ensuring quality across all phases. DISS brings this comprehensive capability to the forefront of the restoration industry, making them an invaluable partner for fire, water, and storm damage recovery. Their integrated approach means fewer headaches and less coordination for property owners, a crucial benefit during the stressful aftermath of a property disaster. Whether the issue is complex water damage requiring mold remediation or extensive fire damage needing structural rebuilds, having one reliable contractor manage the entire process simplifies everything for residents in Farrell, Beaver County, and beyond.
One of the most valuable services offered by DISS is their specialization in disaster relief and restoration work. Living in Pennsylvania means being prepared for various weather challenges, which can lead to anything from basement flooding to fire incidents. DISS's immediate 24/7 emergency response capability is a cornerstone of their service, providing timely mitigation that can drastically reduce the total damage and the overall cost of the restoration project. This dedication to rapid action is consistently highlighted by customers who value efficiency and professionalism during their most challenging times.
Darren’s review, where he notes the quick service, cleanliness, and respectful, courteous nature of the work done to repair blown-in insulation after a roof leak, exemplifies the focus on customer experience. Similarly, another satisfied customer highly recommended DISS after a home water damage incident, stating: “From the initial assessment to the final restoration, their team was incredibly professional, efficient, and thorough. They arrive on time, explained every step of the process, and answered all of my questions with patience. The crew was skilled and paid attention to even the smallest details while working quickly to prevent further damage.” This feedback underscores the company’s commitment to making an “otherwise overwhelming situation” feel “smooth and stress-free.”
In addition to their robust general contracting and restoration capabilities, DISS also provides specialized cleaning and remediation services. Their facility features a dedicated 17,000 square-foot climate-controlled cleaning facility designed specifically for restoring soft and hard contents that have been affected by fire or water. This specialized content restoration process is crucial for recovering personal belongings and valuable items, with DISS setting an impressive mission to recover an average of 85% of contents from a house fire. This level of dedication to salvaging what matters most truly sets them apart as a caring and capable restoration partner in Pennsylvania.
The combination of emergency response, specialized cleaning, comprehensive general contracting, and a clear customer focus makes DISS a go-to choice for those facing property damage in their Pennsylvania service areas. Their experience spans both commercial and residential properties, handling jobs of all sizes across multiple stages of the disaster recovery and repair process.
Location and Accessibility
DISS's main operations are strategically located in Western Pennsylvania, enabling them to serve the surrounding regional communities effectively.
The main office is located at:
712 Spearman Ave, Farrell, PA 16121, USA
From this location, DISS provides professional restoration and general contracting services in Pennsylvania and extends its reach throughout the Midwest. Locally, they are dedicated to serving residents and businesses in several key Pennsylvania counties, including:
- Beaver County, PA
- Butler County, PA
- Crawford County, PA
- Lawrence County, PA
- Mercer County, PA
The facility at 712 Spearman Ave in Farrell is designed with accessibility in mind, offering both a wheelchair-accessible entrance and a wheelchair-accessible parking lot, ensuring that all clients and visitors can easily access their location.
Services Offered
DISS provides a full suite of emergency restoration and general contracting services for residential and commercial properties. These services cover every step of the recovery process, from initial damage mitigation to final construction and repair.
- 24/7 Emergency Service for immediate response
- Fire Damage Restoration
- Fire, Smoke, And Soot Damage cleanup and repair
- Smoke & Soot Removal and thorough cleaning service
- Water Damage Restoration Service
- Flooding Damage and Water Mitigation
- Water Removal Drying and Dehumidifying Cleaning
- Sewage Damage and Sewer Backup cleanup
- Water damage-related cleanup & repair and restoration project management
- Water damage-related mold removal and Mold Remediation
- Antimicrobial And Antifungal Treatments
- Lead Abatement
- Inspection & Assessment of damage
- Boarding Up And Tarping, including Board Up Residential and Building Wrap
- Cleaning & Sanitizing, including Commercial Cleaning and Industrial Cleaning
- General Contracting Services (including post-disaster reconstruction)
- New Construction services
- Foundation repair and replacement
- Roofing, siding, gutters & downspouts and windows installation/repair
- Framing and drywall services
- Electrical and plumbing rough-ins
- HVAC installation and upgrades
- Flooring (tile, hardwood, vinyl, carpet) installation
- Painting, trim, and carpentry
- Insulation & vapor barrier installation
- Specialized Cleaning, including Ultrasonic Blind Cleaning, Air Filtration, and Green Cleaning
Features / Highlights
Choosing DISS means partnering with a general contractor that offers distinct advantages in the restoration field, ensuring a high-quality and stress-free recovery process for both commercial and residential clients in Pennsylvania.
- Full-Service Emergency Restoration: DISS provides an end-to-end solution for disaster recovery, encompassing both emergency cleanup and complete general contracting for reconstruction.
- 24-Hour Emergency Service: Help is available around the clock, 24/7, which is essential for minimizing damage immediately after an incident like a fire or flood.
- Specialized Contents Restoration: The company maintains a 17,000 square-foot climate-controlled cleaning facility dedicated to restoring soft and hard contents, with a mission to recover an impressive 85% of contents from an average house fire.
- Commercial and Residential Expertise: They service properties of all sizes, with extensive experience in both residential and commercial restoration projects.
- Broad Service Area: While based in Farrell, PA, the company serves Beaver, Butler, Crawford, Lawrence, and Mercer counties in Pennsylvania, as well as providing professional restoration services throughout the Midwest.
- Accessibility Focus: The main facility is equipped with a wheelchair-accessible entrance and parking lot, promoting ease of access for all customers.
- Commitment to Detail: Customer reviews consistently praise the team’s professionalism, efficiency, thoroughness, and attention to detail during the cleanup and restoration process.
- Hazardous Material Handling: The team is equipped to handle services like Lead Abatement, ensuring compliance and safety during restoration on older properties.
Contact Information
For emergency restoration services or to inquire about general contracting for your property, DISS can be reached at the following:
Address: 712 Spearman Ave, Farrell, PA 16121, USA
Toll-Free Phone: (800) 553-8426
What is Worth Choosing
For Pennsylvania property owners, especially those in the Western counties, choosing DISS for a general contractor and restoration service is a decision for comprehensive care and specialized expertise. The most compelling reason to choose this company is their seamless, single-provider approach to disaster recovery. When your property is damaged by fire or water, you face two distinct problems: the urgent cleanup/mitigation and the long-term reconstruction/repair. DISS expertly manages both. They provide immediate 24/7 emergency mitigation to secure your property and stop further damage, and then, as your general contractor, they take the project through all necessary repairs—from foundation work and framing to final finishes like flooring and painting.
This all-in-one capability eliminates the stress of coordinating multiple contractors. Imagine dealing with a devastating fire; you need a restoration crew for cleanup, a specialized facility for content recovery, and a general contractor for the rebuild. DISS is all three, which ensures efficiency, accountability, and consistent quality across the entire project timeline. Their successful mission to save an average of 85% of contents from a fire, utilizing their advanced climate-controlled facility, further showcases their commitment to not just fixing the structure but preserving your life's belongings. Furthermore, the genuine care and professionalism highlighted by customer feedback—praising their courteous nature and ability to make an overwhelming situation stress-free—confirms that DISS prioritizes the customer experience as much as the quality of their craftsmanship. For an integrated, expert, and empathetic approach to property restoration and general contracting in Pennsylvania, DISS provides an exceptional value.
DISS Services
Fire Damage Restoration Service
- Water damage-related cleanup & repair
- Water damage-related mold removal
- 24/7 Emergency Service
- Air Filtration
- Antimicrobial And Antifungal Treatments
- Board Up Residential
- Boarding Up And Tarping
- Building Wrap
- Cleaning & Sanitizing
- Cleaning And Deodorizing
- Commercial Buildings
- Commercial Cleaning
- Commercial Roofing Services
- Dehumidifying Cleaning
- Dry Cleaner
- Drying & Dehumidifying
- Fire And Water Damage Restoration
- Fire Extinguisher
- Fire, Smoke, And Soot Damage
- Fireline Systems
- Flooding Damage
- Green Cleaning
- Hazardous Materials
- Industrial Cleaning
- Inspection & Assessment
- Lead Abatement
- Mold Remediation
- New Construction
- Pressure Cleaning
- Repair Restoration
- Residential Building
- Restoration Project
- Sewage Backups
- Sewage Damage
- Sewer Backup
- Smoke & Soot Removal
- Thorough Cleaning Service
- Ultrasonic Blind Cleaning
- Water Mitigation
- Water Removal Drying
- Window Cleaning
DISS Details
Accessibility
- Wheelchair accessible entrance
- Wheelchair accessible parking lot
DISS Location
DISS Reviews
roofvendorwaterinsurancecompany
★ 5★ 4★ 3★ 2★ 1Darren did work to repair blown-in insulation that was moved to repair a roof leak. He was quick, cleaned up & was very respectful & courteous.
Sep 11, 2025 · smithdigitalvideoI recently had the pleasure of working with DISS after my home was affected by water damage and I can’t recommend them highly enough. From the initial assessment to the final restoration, their team was incredibly professional, efficient, and thorough. They arrive on time, explained every step of the process, and answered all of my questions with patience. The crew was skilled and paid attention to even the smallest details while working quickly to prevent further damage.What impressed me most was how smooth and stress-free they made an otherwise overwhelming situation. I couldn’t be happier with the results. I highly recommend DISS to anyone in need of reliable, high-quality restoration services.
Jan 10, 2025 · Karen KosarDISS put my house back together after an accidental flooding. The clean up team that came to clean up the flood and then again to clean up the construction dust was FANTASTIC. Pete and Serena are hard workers and did a thorough job. Five Stars for their part in this job. Joe, the contractor, was easy to work with and friendly. He corrected errors and made sure the final job was done well and correctly. James and Yvonne did the reconstruction work and paid attention to detail, working hard for 3 straight days to ensure our house was livable again. I'm grateful for each team member that worked to put my house back in order.The reason for 4 stars is the incredibly long wait for the work to be completed. We waited 11 weeks from when the flooding occurred to when everything was fixed. It took a week to dry out the house and 3-4 days to put it back together, but the process was drawn out and a bit frustrating. The first crew, Luke and one other guy, that came to put the house back together rushed the job while working on other projects and coming to our house only in the evenings for an hour or two at a time. They made a mess that needed to be ripped out and started over from the beginning. They did not come back after that.
Dec 11, 2024 · Barbara FehrDue to circumstances I chose to use DISS based a Nationwide vendor preferred list. At the time they were the ONLY one available on the list after storm damage, all other local vendors were not available....which should have been my first RED FLAG (NOTE: after the first job, Nationwide advised me they had been removed from the Preferred list). DISS provided an estimate for garage roof , other garage damage, and house fan and gable vent. I was advised that I needed to put down almost 100% of the job in order to get it scheduled. Anything less would result in a delay. second RED FLAG...I reluctantly agreed due to preferred vendor status at the time. They were not able to give me a schedule date, but called a few days before they were coming. ......third RED FLAG.On the day they showed up, they had an attic vent rather than a fan, and a gable vent in the wrong color , after waiting for the correct parts, the gable vent was installed crooked, with the installer insisting it wasn't...fourth RED FLAGDISS had informed me they hired a subcontractor for the job. The subcontractor informed me they also hired subcontractors. The crew was mostly non-English speaking, who appeared to be day laborers. It was extremely unsettling to have a woman waiting in a parked car with a baby during the duration on the job. My MISTAKE was not asking to see the Niles Work Permit and registration and Workman's Comp paperwork. fifth RED FLAGReplacement to my house roof was then approved. In discussion with Insurance, they advised me that DISS is no longer on their vendor list(would not tell me why) and that I can use another company. sixth RED FLAGI had a local reputable roofer with a longtime local crew give about the same estimate as DISS, but used a better quality shingle with a better guarantee, and schedule the job in advance, without the demand of near full payment before the job.Several months later the installed attic fan was making rattling, suspicious noises . After 2 calls to DISS and a callback from the scheduling manager who said he would dispatch someone , no one has called me or showed up to look at the fan. My guess after voicing my concerns with DISS, they have chosen not to stand by their work.*******Be sure to review the Better Business Bureau cases for DISS******* Be cautious/suspicious with the positive reviews for DISS. At least one of the reviews is from a current employee******* Had to give at least 1 star in order for the review to be posted*******WOULD ADVISE AGAINST USING THIS COMPANY
Jun 11, 2024 · Cat & AlOur basement flooded due to sump pump failure and also because we contracted in a waterproofing company that has failed us. DISS Water Restoration was referred as vendor through our homeowners insurance and I’m so happy that they were! We have never heard of this company before, and never experienced anything like this. The staff was extremely responsive, professional, And took care of us like they were family. Can’t recommend them enough!!!
Feb 26, 2024 · Teri Daley
More Water Damage Restoration Near Me
Jancsar In & Out Painting5.0 (24 reviews)#0000, Wheatland, PA 16161, USA
Pro Drywall Plastering and Painting4.0 (18 reviews)479 Clarksville Rd, Hermitage, PA 16148, USA
Baker's Waterproofing4.0 (55 reviews)701 N Hermitage Rd Ste 25, Hermitage, PA 16148, USA
Rainbow Restoration of Youngstown3.0 (43 reviews)116 Linden Ave, Youngstown, OH 44505, USA
Dan Faith Construction LLC4.0 (74 reviews)420 Youngstown Warren Rd, Niles, OH 44446, USA
Water-Rid Basement Waterproofing5.0 (7 reviews)1221 N Meridian Rd, Youngstown, OH 44515, USA
Americon Restoration of The Ohio Valley4.0 (165 reviews)1112 N Meridian Rd, Youngstown, OH 44509, USA
Aqua Solutions Basement Waterproofing LLC5.0 (66 reviews)286 Orangeville Rd, Greenville, PA 16125, USA
ServiceMaster Emergency Experts by Gault4.0 (11 reviews)64 Sharon Rd, Greenville, PA 16125, USA
AK Water Works Plumbing & Drain4.0 (697 reviews)4248 N River Rd NE, Warren, OH 44484, USA
Rewcon Home Improvements5.0 (33 reviews)4812 W State St, Hillsville, PA 16132, USA
G. S. Kusich Construction inc.4.0 (20 reviews)380 Fredonia Rd, Greenville, PA 16125, USA
Categories
Top Visited Sites
NextGen Greenacres Water Damage Restoration Pros0.0 (0 reviews)
Mr. Handyman of West Augusta and Thomson4.0 (96 reviews)
Rutman Restoration5.0 (33 reviews)
SERVPRO of SW San Jose4.0 (76 reviews)
Mold Guy LLC5.0 (4 reviews)
Rainbow Restoration of Milwaukee5.0 (3 reviews)Top Water Damage Restoration Searches
Trending Damage Repair Guides Posts
Restoring Water-Damaged Electronics: What Works and What Doesn’t
How to Restore Water-Damaged Upholstery - Expert Tips and Solutions
How to Restore Water-Damaged Photographs: A Step-by-Step Guide
How to Clean Water-Damaged Carpeting and Area Rugs
How to Remove Mold After Water Damage
Why It's Important to Address Water Damage Immediately | Home Repair Tips
